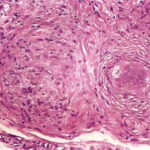

Subcutaneous sarcoidosis = الساركوئيد تحت الجلد
Sarcoidosis
|
Sarcoidosis is a granulomatous disease, often systemic, of undetermined cause. A distinction is made between the rare subacute, transient type of sarcoidosis and the usual chronic, persistent type. |
|
In subacute, transient sarcoidosis, erythema nodosum is associated with hilar adenopathy, fever, and, in some cases, migrating polyarthritis and acute iritis. The disease subsides in almost all patients within a few months without sequelae. Cutaneous manifestations other than erythema nodosum do not occur . Occasionally, there is enlargement of some of the subcutaneous lymph nodes, such as the submental or cervical nodes . |
|
In systemic sarcoidosis, cutaneous lesions are encountered in approximately one fourth of patients who are seen in medical departments . In contrast, cutaneous lesions are the only manifestation of sarcoidosis in about one fourth of patients with sarcoidosis seen in dermatologic departments . |
|
In the United States, this disorder is much more common and is more severe in African Americans . It is rare in children . A rare genetic disorder, Blau's syndrome, may present in childhood and mimic sarcoidosis. This autosomal dominant disorder is marked by granulomatous inflammation of the skin, uveal tract, and joints, sparing the lungs . |
|
The most common cutaneous lesions of sarcoidosis are brown-red or purple papules and plaques . Through central clearing, annular or circinate lesions may result. When papules or plaques of sarcoidosis are situated on the nose, cheeks, and ears, the term lupus pernio is applied . This presentation has been associated with upper respiratory involvement and greater disease severity . |
|
A rare form of sarcoidosis is its lichenoid variant, in which small, papular lesions occur . Very rare manifestations of sarcoidosis include erythrodermic, ichthyosiform, atrophic, ulcerating, verrucous, angiolupoid, hypopigmented, alopecic, and morpheaform variants. In erythrodermic sarcoidosis, the erythroderma may be generalized or may consist of extensive, sharply demarcated, brown-red, slightly scaling patches with little or no palpable infiltration . In ichthyosiform sarcoidosis, ichthyotic changes favor the lower extremities , but at times they also may be present elsewhere on the skin . Rarely, there are extensive atrophic lesions . They may undergo ulceration . Multiple ulcers have been described also in plaquelike lesions . Angiolupoid sarcoid is characterized by a prominent telangiectatic component . Lesions of hypopigmented sarcoid appear as macules with or without an associated papular or nodular component . Subcutaneous nodules of sarcoidosis are also rare. Originally described by Darier and Roussy , they may |
|
occur in association with other cutaneous lesions or alone . Up to 80% to 90% of patients with subcutaneous sarcoidosis may have associated systemic disease . Sarcoidosis has been described in AIDS patients , and a transient form of chronic sarcoidosis has been reported in patients with hepatitis C undergoing treatment with interferon alfa and ribavirin |
|
Systemic sarcoidosis occasionally coexists with granuloma annulare . Cutaneous lesions of sarcoidosis may localize to areas of scarring, as in herpes zoster scars . Tattoos , exogenous ochronosis , or other exogenous materials in the skin may serve as a nidus for cutaneous lesions in patients with sarcoidosis. Two studies demonstrated polarizable foreign material in approximately 20% of cutaneous sarcoidal lesions from patients with systemic sarcoidosis . |
|
Histopathology. The lesions of erythema nodosum occurring in subacute, transient sarcoidosis have the same histologic appearance as "idiopathic" erythema nodosum . |
|
Like lesions in other organs, the cutaneous lesions of chronic, persistent sarcoidosis are characterized by the presence of circumscribed collections of epithelioid histiocytes-so-called epithelioid cell tubercles-which show little or no necrosis . |
|
The papules, plaques, and lupus pernio-type lesions show variously sized aggregates of epithelioid cells scattered irregularly through the dermis with occasional extension into the subcutis (. In the erythrodermic form, the infiltrate shows small granulomas in the upper dermis intermingled with numerous lymphocytes and, rarely, also giant cells . Typical sarcoidal granulomas are found in the ichthyosiform lesions , in ulcerated areas , and in atrophic lesions . Verrucous sarcoid exhibits prominent associated acanthosis and hyperkeratosis . Biopsies of |
|
hypopigmented sarcoid may reveal granulomas, which may have a perineural component or fail to reveal granulomas . In subcutaneous nodules, larger epithelioid cell tubercles lie in the subcutaneous fat . |
|
In typical cutaneous lesions of sarcoidosis, the well-demarcated islands of epithelioid cells contain few, if any, giant cells. Those that are present are usually of the Langhans type. A moderate number of giant cells can be found in old lesions. These giant cells may be large and irregular in shape. In a minority of cases, giant cells contain asteroid bodies or Schaumann bodies . Asteroid bodies , which are more common, are star-shaped eosinophilic structures that, when stained with phosphotungstic acid-hematoxylin, produce a center that is brown-red with radiating blue spikes . Schaumann bodies are round or oval, laminated, and calcified, especially at their periphery. They stain dark blue because of the presence of calcium. Neither of these two bodies is specific for sarcoidosis: They have been observed in a variety of other granulomas, including those of leprosy, tuberculosis, foreign-body reactions, and necrobiotic xanthogranuloma . |
|
Classically, sarcoid has been associated with only a sparse lymphocytic infiltrate, particularly at the margins of the epithelioid cell granulomas . Because of the scarcity of lymphocytes, the granulomas have been referred to as "naked" tubercles. However, lymphocytic infiltrates in sarcoid may occasionally be dense, as in tuberculosis . Occasionally, small foci of fibrin or necrosis showing |
|
eosinophilic staining is found in the center of some of the granulomas . A reticulum stain of sarcoid reveals a network of reticulum fibers surrounding and permeating the epithelioid cell granulomas. If the granulomas of sarcoidosis involute, fibrosis extends from the periphery toward the center, with gradual disappearance of the epithelioid cells . Fibrosis, however, is minimal to absent in most examples of sarcoidosis, with the exception of the morpheaform variant, where it is prominent {191}. Other features that may sometimes be seen include elastophagocytosis, increased dermal mucin, and lichenoid inflammation . |
|
Systemic Lesions. The lungs are the most commonly involved organ in the chronic, persistent type of sarcoidosis, and respiratory symptoms are present in approximately 50% of patients . The lesions may be either nodular or diffuse with extensive parenchymal fibrosis. |
|
In about 25% of the patients, ocular manifestations occur, most commonly chronic iridocyclitis. Splenomegaly is present in about 17%. In approximately12%, osseous granulomas are present, most commonly in the phalanges of the fingers and toes. Involved phalanges appear swollen and deformed, often sausage-shaped . The skull may show circumscribed lytic lesions . About 8% of the patients have involvement of large salivary glands, usually the parotid. In about 5%, one encounters paresis of a cranial nerve, most commonly of the facial nerve . Oral mucosal involvement occurs very rarely . Asymptomatic enlargement of the hilar lymph nodes is present in 70%, of peripheral lymph nodes in 30%, and of the liver in 20% of the patients . Sarcoidosis, although usually a benign disease, is fatal in approximately 5% of patients . The most common cause of death from sarcoidosis is right ventricular failure resulting from massive pulmonary involvement. Pulmonary hemorrhage and superimposed tuberculosis are rare causes of death. Another potentially fatal complication is renal insufficiency resulting from hypercalcemia and hypercalciuria or from sarcoidal glomerulonephritis . In very rare instances, death results from massive involvement of the myocardium or liver . Hypopituitarism from involvement of either the pituitary gland or the hypothalamus is also a rare fatal complication . |
|
The diagnosis of sarcoidosis in a patient with systemic disease is based on clinical presentation, biopsy findings, and exclusion of other granulomatous processes. If skin lesions are present, they are an obvious choice for biopsy. In the absence of skin lesions, a Kveim test was frequently used in the past. The Kveim test involves intradermal injection of antigen derived from heat-sterilized suspension of sarcoidal tissue, particularly spleen or lymph node. The site is sampled 6 weeks later, with a positive result being the formation of a sarcoid-like granuloma . The test has a sensitivity of about 80%, with false-positive reactions occurring in less than 2% of cases . However, Kveim antigen is neither widely available nor approved by the U.S. Food and Drug Administration. It is infrequently used . The most accepted alternative approach for confirming a presumptive diagnosis of systemic sarcoidosis is fiberoptic bronchoscopy with transbronchial lung biopsy . Endobronchial biopsy has also been shown to be useful , as has asymptomatic gastrocnemius muscle biopsy . Less specific ancillary tests, such as serum angiotensin-converting enzyme levels, can provide supportive data . |
|
Pathogenesis. The cause of sarcoidosis is unknown, and the disease may not have the same pathogenesis in all individuals. Alterations in immunologic status have long been recognized, including hypergammaglobulinemia, impaired delayed-type hypersensitivity reactions to cutaneous antigens (anergy), and a shift of helper T lymphocytes from peripheral blood to sites of disease activity . However, these immunologic phenomena may represent a response to an as-yet-unidentified antigen . Mycobacteria, especially cell-wall-deficient forms, have been postulated to represent the antigen source . Mycobacterium tuberculosis has been implicated by some studies, whereas others have suggested atypical mycobacteria . Other infectious causes such as Rickettsia have also been suggested. |
|
Electron microscopic examination of epithelioid cells fails to show any evidence of bacterial fragments, unlike the macrophages seen in granulomas caused by mycobacteria, although the cells contain primary lysosomes, some autophagic vacuoles, and complex, laminated residual bodies . The giant cells form through the coalescence of epithelioid cells with partial fusion of their plasma membranes. Schaumann bodies likely arise from laminated |
|
residual bodies of Iysosomes. Asteroid bodies consist of collagen showing the typical 64- to 70-nm periodicity. It seems likely that this collagen is trapped between epithelioid cells during the stage of giant-cell formation .
Differential Diagnosis. The histologic differentiation of sarcoidosis from lupus vulgaris may be very difficult, and it is occasionally impossible. There is no absolute histologic criterion by which the two diseases can be differentiated with certainty. However, as a rule, the infiltrate in sarcoidosis lies scattered throughout the dermis, whereas the infiltrate in lupus vulgaris is located close to the epidermis. Furthermore, sarcoidosis usually shows few lymphoid cells at the periphery of the granulomas, giving them the appearance of "naked" granulomas. By contrast, lupus vulgaris often shows a marked inflammatory reaction around and between the granulomas. The granulomas of sarcoidosis usually show much less central necrosis than the granulomas of lupus vulgaris ; however, not all biopsies of tuberculosis show necrosis, and some biopsies of sarcoid do. The epidermis in sarcoidosis is usually normal or atrophic. In lupus vulgaris, in addition to atrophy, areas of ulceration, acanthosis, and pseudocarcinomatous hyperplasia are not uncommon. The absence of identifiable mycobacteria with acid-fast stain cannot be used to exclude tuberculosis because the organisms in lupus vulgaris are scarce and may be difficult or impossible to find. Foreign-body granulomas can also resemble sarcoidosis. Polariscopic examination in search of doubly refractile material, such as silica, should be performed on biopsies suspected of being sarcoidosis. The presence of foreign material does not exclude a concurrent diagnosis of sarcoidosis . The papular type of acne rosacea occasionally shows "naked" tubercles indistinguishable from those of sarcoidosis, but unlike sarcoid, they are usually perifollicular. Tuberculoid leprosy, which may show granulomas in association with only a sparse lymphocytic infiltrate, can also be difficult to distinguish from sarcoidosis. Only 7% of cases of tuberculoid leprosy show acid-fast bacilli, and then only a few, so that they may easily be overlooked . The most likely place to find bacilli is within degenerated dermal nerves (the granulomas of tuberculoid leprosy form around dermal nerves that are undergoing necrosis). The granulomas of tuberculoid leprosy show small areas of central necrosis more often than those of sarcoidosis. In addition, the granulomas of tuberculoid leprosy, in contrast with those of sarcoidosis, follow nerves and therefore often appear elongated . Clinical correlation may be required to distinguish between these two diseases. For example, in the United States, leprosy virtually can be excluded if a patient has not been in an endemic area (either in a foreign country or where it is carried in armadillos domestically, e.g., Texas and Louisiana) or has not had prolonged close contact with another individual with the disease |